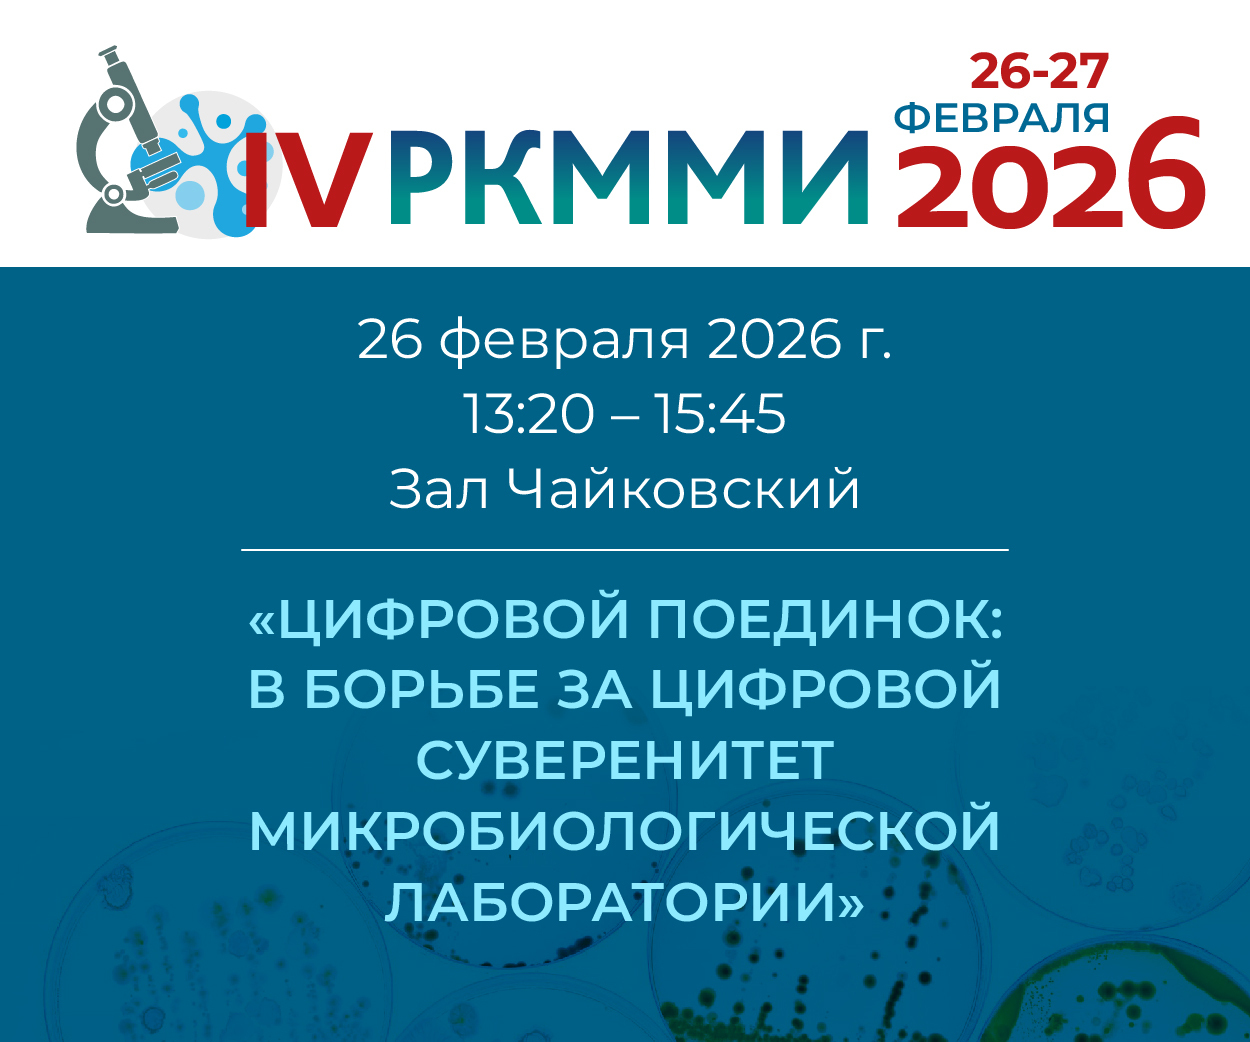

Приглашаем главных внештатных специалистов федеральных округов по медицинской микробиологии, заведующих микробиологическими лабораториями, врачей - микробиологов посетить секцию «Цифровой поединок: архитекторы экосистем в борьбе за цифровой суверенитет микробиологической лаборатории».
В рамках мероприятия состоится эксклюзивная презентация с результатами анализа цифровизации микробиологических лабораторий в регионах. Мы увидим «где мы сегодня?». Руководители и разработчики ведущих лабораторных-информационных систем представят свои решения. Узнаем о возможностях, архитектурных особенностях и конкурентных преимуществах из первых уст!
Самая жаркая часть – дебаты. Мы ожидаем живой и интерактивный диалог с залом, где можно будет задать самые неудобные вопросы и в прямом диалоге с вендорами и коллегами найти практические решения.
Наша цель — дискуссия, которая станет катализатором перемен, чтобы цифровая трансформация вашей лаборатории и всей медицинской организации перешла на качественно новый путь развития — осознанный, суверенный и эффективный.
Время и место проведения: 26 февраля 2026 г., 13:20 - 15:45. Зал Чайковский
В рамках мероприятия состоится эксклюзивная презентация с результатами анализа цифровизации микробиологических лабораторий в регионах. Мы увидим «где мы сегодня?». Руководители и разработчики ведущих лабораторных-информационных систем представят свои решения. Узнаем о возможностях, архитектурных особенностях и конкурентных преимуществах из первых уст!
Самая жаркая часть – дебаты. Мы ожидаем живой и интерактивный диалог с залом, где можно будет задать самые неудобные вопросы и в прямом диалоге с вендорами и коллегами найти практические решения.
Наша цель — дискуссия, которая станет катализатором перемен, чтобы цифровая трансформация вашей лаборатории и всей медицинской организации перешла на качественно новый путь развития — осознанный, суверенный и эффективный.
Время и место проведения: 26 февраля 2026 г., 13:20 - 15:45. Зал Чайковский